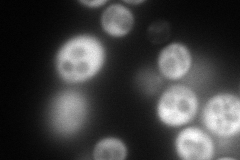
YGR214W
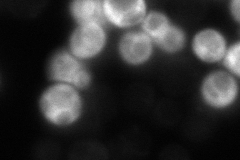
YGR214W
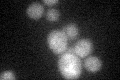
YGR214W

View description
Protein component of the small (40S) ribosomal subunit, nearly identical to Rps0Bp; required for maturation of 18S rRNA along with Rps0Bp; deletion of either RPS0 gene reduces growth rate, deletion of both genes is lethal
Localization:
Intensity:
Fold change:
Significance:
-
C’ GFP library in SD

cytosol19.47 -
N' NOP1pr-GFP in SD
cytosol275.151 -
N' TEF2pr-mCherry in SD

ER,vacuole0 -
N' NATIVEpr-GFP in SD
cytosol28.3578 -
N' TEF2pr-VC and Cyto-VN in SD

cytosol93.8324 -
C’ GFP library in SD+DTT
cytosol14.740.75No -
C’ GFP library in SD+H2O2

cytosol15.660.8No -
C’ GFP library in Starvation Media

cytosol13.930.71No -
C’ GFP library on the background of Pup2-DaMP

cytosol -
C’ GFP library on the background of CCT mutant

cytosol20.8031.06801No
